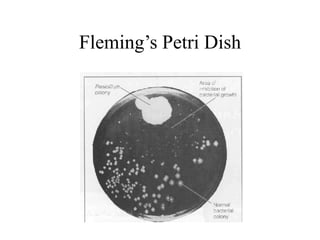
Fleming’s Petri Dish

This document discusses antimicrobial agents known as antibiotics. It defines antibiotics as substances produced by microorganisms that inhibit the growth of or destroy other microbes. The document outlines the selective toxicity of antibiotics, noting they affect bacteria differently than human cells. It provides examples of common antibiotics including penicillins and cephalosporins, describing their mechanisms of action in inhibiting bacterial cell wall synthesis and their importance in history as some of the first widely used antibiotics. The summary briefly touches on antibiotic resistance as well as adverse effects and interactions.